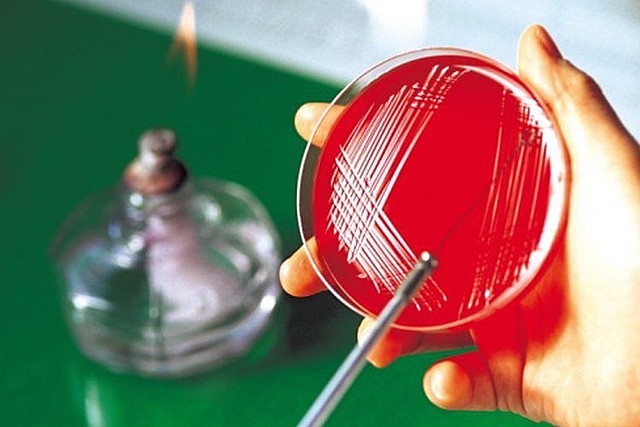
Nacimiento de la microbiologia

-
-
-
-
-
en el libro de Manú se indica como debe de realizarse la carnización y faenado de los animales
-
-
-
-
-
-
-
por parte de un quimico sueco
-
-
-
-
-
Aporta:
- La pasteurización
-La fermentación como proceso biológico -
-
-
-
-
-
-
-
-
alrededor de dos cuestiones
-Teoría de la generación espontanea
- Teoría microbiana de enfermedades infecciosas -
-
-
-
-
-
-
-
-
Programa Especial para la Seguridad Alimentaria
-
-
el mercado internacional sufre los efectos de Encefalopatía Espongiforme Bovina y se restringe la importacion de bovinos y derivados
-
FAO adptó medidas estrictas para convatir el virus del SARS y restructura al sector avicola
Plan projects on a visual timeline
Map milestones, phases, deadlines, and key events in one place so the sequence is easier to see and share. Timetoast is a timeline maker for work, school, research, and stories.